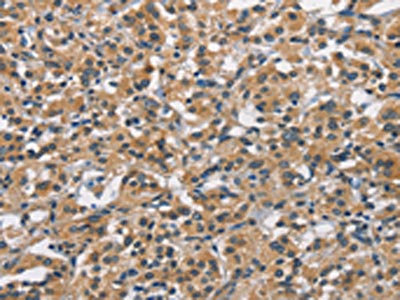

-
中文名稱:APOL1兔多克隆抗體
-
貨號:CSB-PA199459
-
規格:¥1100
-
圖片:
-
The image on the left is immunohistochemistry of paraffin-embedded Human gastic cancer tissue using CSB-PA199459(APOL1 Antibody) at dilution 1/40, on the right is treated with synthetic peptide. (Original magnification: ×200)
-
The image on the left is immunohistochemistry of paraffin-embedded Human thyroid cancer tissue using CSB-PA199459(APOL1 Antibody) at dilution 1/40, on the right is treated with synthetic peptide. (Original magnification: ×200)
-
Gel: 10%SDS-PAGE, Lysate: 20 μg, Lane: Human plasma tissue, Primary antibody: CSB-PA199459(APOL1 Antibody) at dilution 1/300, Secondary antibody: Goat anti rabbit IgG at 1/8000 dilution, Exposure time: 2 seconds
-
-
其他:
產品詳情
-
Uniprot No.:
-
基因名:
-
別名:APO L antibody; Apo-L antibody; ApoL antibody; APOL I antibody; ApoL-I antibody; APOL1 antibody; APOL1_HUMAN antibody; APOLI antibody; Apolipoprotein L antibody; Apolipoprotein L I antibody; Apolipoprotein L-I antibody; Apolipoprotein L1 antibody; FSGS4 antibody
-
宿主:Rabbit
-
反應種屬:Human
-
免疫原:Synthetic peptide of Human APOL1
-
免疫原種屬:Homo sapiens (Human)
-
標記方式:Non-conjugated
-
抗體亞型:IgG
-
純化方式:Antigen affinity purification
-
濃度:It differs from different batches. Please contact us to confirm it.
-
保存緩沖液:-20°C, pH7.4 PBS, 0.05% NaN3, 40% Glycerol
-
產品提供形式:Liquid
-
應用范圍:ELISA,WB,IHC
-
推薦稀釋比:
Application Recommended Dilution ELISA 1:1000-1:2000 WB 1:200-1:1000 IHC 1:50-1:200 -
Protocols:
-
儲存條件:Upon receipt, store at -20°C or -80°C. Avoid repeated freeze.
-
貨期:Basically, we can dispatch the products out in 1-3 working days after receiving your orders. Delivery time maybe differs from different purchasing way or location, please kindly consult your local distributors for specific delivery time.
-
用途:For Research Use Only. Not for use in diagnostic or therapeutic procedures.
相關產品
靶點詳情
-
功能:May play a role in lipid exchange and transport throughout the body. May participate in reverse cholesterol transport from peripheral cells to the liver.
-
基因功能參考文獻:
- Plasma concentrations of TNFR1, TNFR2, and KIM1 are independently associated with renal outcome and improve discrimination or reclassification of African ancestry individuals with a high-risk APOL1 genotype and preserve renal function. PMID: 29685497
- APOL1 risk variants did not associate with subclinical markers of atherosclerosis or left ventricular hypertrophy in middle-aged black adults with preserved kidney function. PMID: 29042080
- Review of the role of APOL1 in kidney disease in children and young adults of African ancestry. APOL1 explains almost 70% of the excess risk of kidney disease in those of African descent, and is common in children with glomerular disease. PMID: 29406442
- Association of chronic kidney disease with APOL1 risk alleles was not identified in Aboriginal people in remote areas of Australia. PMID: 28314584
- APOL1 Risk Variant is associated with focal segmental glomerulosclerosis. PMID: 29531077
- APOL1, alpha-thalassemia, and BCL11A variants as a genetic risk profile for progression of chronic kidney disease in sickle cell anemia. PMID: 27658436
- Among blacks with established moderate CKD, the APOL1 high-risk variants are associated with greater risk of incident proteinuria. After proteinuria onset, kidney function declines more rapidly but does not differ by APOL1 risk status. PMID: 29051146
- In individuals at risk for nondiabetic kidney disease based on African ancestry, the majority of that risk can be explained by two variants in the APOL1 gene. PMID: 29110756
- Considering APOL1 evolution also may help us understand how APOL1 risk variants cause kidney disease in modern humans. PMID: 29110757
- APOL1 variants are associated with HIV-associated nephropathy(HIVAN), a podocyte disease,but not with HIV-immune complex disease, primarily a disease of the mesangium. PMID: 29110758
- the associations of the APOL1 risk variants with microalbuminuria, incident CKD, and subsequent kidney function decline implicate a potential role in both the development and progression of CKD. Unlike the consistent association with CKD, the association of the APOL1 risk variants with cardiovascular disease is less clear. PMID: 29110759
- The presence of two APOL1 renal risk variants in deceased donors shortens survival of their renal allografts. No study has examined the potential interaction of APOL1 genotype of the donors, deceased or living, and recipients. PMID: 29110760
- expression of G1 or G2 APOL1 results in significantly more cell death compared with wild-type APOL1 (G0) in various human cells in culture PMID: 29110762
- Genetic variant in apolipoprotein L1 is not associated with preterm birth in African American population. PMID: 27638911
- This is the first report of a specific association of APOL1 with small vessel disease (SVD) ischemic stroke. PMID: 28975602
- study found strong evidence for no association with Trypanosoma brucei rhodesiense Human African trypanosomiasis and APOL1 G2 in two Ugandan populations PMID: 29470556
- APOL1 variants are not associated with longitudinal blood pressure in blacks. PMID: 28545715
- Letter: no APOL1 risk allele variants in Indian patients with chronic kidney disease. PMID: 27633872
- APOL1 copy number variations may be not associated with susceptibility to focal segmental glomerulosclerosis in Chinese population. PMID: 28494221
- APOL1 Genetic Variations are associated with acute rejection. PMID: 27862962
- These results implicate both forms of human African trypanosomiasis in the selection and persistence of otherwise detrimental APOL1 kidney disease variants. PMID: 28537557
- APOL1 variant is associated with End-Stage Renal Disease. PMID: 27588375
- The enhanced expression of GRP78 by podocytes expressing APOL1 variants would indicate endoplasmic reticulum (ER) stress. PMID: 28385815
- Among patients with CKD attributed to hypertension, those with the APOL1 high-risk genotype were more likely to experience a steady decline trajectory in eGFR than those without the APOL1 high-risk genotype. These findings suggest a persistent underlying pathophysiologic process in those patients with the APOL1 high-risk genotype. PMID: 27230965
- APOL1 Gene variation is associated with end-stage renal disease. PMID: 27997071
- Apolipoprotein L1 and apolipoprotein A-IV and their association with kidney function PMID: 27870653
- Data suggest that APOL1 confers chloride-selective permeability to preformed phospholipid vesicles; this selectivity is strongly pH-sensitive, with maximal activity at pH 5 and little activity above pH 7; APOL1 permease activity requires calcium ions; APOL1 stably associates with phospholipid vesicles, requiring low pH and presence of negatively charged phospholipids for maximal binding. PMID: 28918394
- Strict blood pressure control during chronic kidney disease associates with a lower risk of death in blacks with the high-risk CKD APOL1 genotype. PMID: 27927600
- Divergent intracellular biological pathways of ancestral and variant APOL1 may explain a worsened prognosis as demonstrated in Systemic Lupus Erythematosus. PMID: 28265848
- Roles of APOL1 G1 and G2 variants in sickle cell disease patients: kidney is the main target. PMID: 28699644
- Two APOL1 renal-risk variants are associated with longer dialysis survival in African Americans with non-diabetic end-stage renal disease. PMID: 27157696
- The frequency of APOL1 risk variants ranged from 7.0% to 11.0%. PMID: 28732083
- The synergy of circulating factor suPAR and APOL1 G1 or G2 on alphavbeta3 integrin activation is a mechanism for CKD. PMID: 28650456
- Among African Americans with hypertension-attributed chronic kidney disease, APOL1 risk variants were not associated with an overall risk for cardiovascular disease although some signals for cardiovascular mortality were noted. PMID: 28572159
- The proteomic profile of apoL1 is modified in HDLs of high cardiovascular risk patients, and apoL1 plasma levels are significantly lower in serum and in HDL3 of patients that will suffer an adverse cardiac event within 3 years. PMID: 27112635
- Relationships between APOL1 kidney risk variants and cardiovascular disease (CVD) susceptibility and CVD-related death remain controversial. Some studies detected an increased risk for CVD, whereas others support protection from death and subclinical CVD and cerebrovascular disease PMID: 28143671
- mice with podocyte-specific expression of either APOL1 risk allele (G1 or G2), but not of the G0 allele, develop functional (albuminuria and azotemia), structural (foot-process effacement and glomerulosclerosis) and molecular (gene-expression) changes that closely resemble human kidney disease. Expression of the risk-variant APOL1 alleles interferes with endosomal trafficking and blocks autophagic flux. PMID: 28218918
- APOL1 single nucleotide polymorphisms are associated with nephropathy. PMID: 26152403
- risk alleles are associated with higher systolic blood pressure and earlier hypertension diagnoses in young African Americans PMID: 28335839
- We report an unadjusted incidence of 1.2 CKD cases/100 person-years (95% CI: 0.5 to 2.5) in PHIV youth carrying APOL1 high-risk genotypes, with important implications for sub-Saharan Africa PMID: 27035887
- Overall, our results suggest podocyte depletion could predispose individuals with APOL1 risk genotypes to kidney disease in response to a second stressor, and add to other published evidence associating APOL1 expression with preeclampsia PMID: 27026370
- This new Drosophila model uncovers a novel mechanism by which upregulated expression of APOL1-G1 could precipitate renal disease in humans. PMID: 27864430
- Results suggest a pivotal role for mitochondrial dysfunction in APOL1-associated kidney disease PMID: 27821631
- Among blacks, the APOL1 high-risk genotype associated only with higher risk of end-stage renal disease in a fully adjusted analysis. Black race and APOL1 high-risk status were associated with faster eGFR decline PMID: 26966015
- GSTM1 null and APOL1 high-risk alleles deleteriously affect chronic kidney disease progression among blacks with hypertension, and subjects with both GSTM1 null and APOL1 high-risk genotypes had highest risk of adverse renal outcomes PMID: 26940095
- Our findings indicate that the presence of risk disease risk variants of APOL1 is permissive of HIV-1 persistence in human podocytes in synergy with IL-1beta, a cytokine that characterizes the inflammatory milieu of acute and chronic phases of HIV-1 infection. PMID: 27599995
- We show that the levels of one member of the family, apolipoprotein L1 (apoL1) is higher in papillary thyroid carcinoma compared to normal tissue. PMID: 27157405
- APOL1 genotype may provide additional diagnostic information to traditional clinical variables in predicting underlying FSGS spectrum lesions in blacks who are HIV positive. PMID: 26668025
- The homozygous N264K ApoL1 variant may be at increased risk of contracting human African trypanosomiasis. PMID: 27073096
- We examined whether APOL1 G1 and G2 renal-risk variant serum concentrations or lipoprotein distributions differed from nonrisk G0 APOL1 in African Americans without nephropathy. PMID: 26586272
顯示更多
收起更多
-
相關疾病:Focal segmental glomerulosclerosis 4 (FSGS4)
-
亞細胞定位:Secreted.
-
蛋白家族:Apolipoprotein L family
-
組織特異性:Plasma. Found on APOA-I-containing high density lipoprotein (HDL3). Expressed in pancreas, lung, prostate, liver, placenta and spleen.
-
數據庫鏈接:
Most popular with customers
-
-
YWHAB Recombinant Monoclonal Antibody
Applications: ELISA, WB, IHC, IF, FC
Species Reactivity: Human, Mouse, Rat
-
Phospho-YAP1 (S127) Recombinant Monoclonal Antibody
Applications: ELISA, WB, IHC
Species Reactivity: Human
-
-
-
-
-